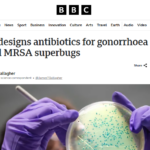

画像:36Kr Japanより引用
中国深圳に世界初のロボット店舗「6S店」が開設され、2025年7月28日にオープニングイベントが行われました。
「6S店」とは、中国の自動車業界で一般的な販売・部品交換・アフターサービス・情報提供を一体化した「4S店」を基盤にしつつ、新たに「レンタル」と「パーソナライズ(個別カスタマイズ)」を加えた六位一体のサービス拠点です。ロボットの販売や修理に加え、利用者の多様なニーズに合わせたカスタマイズや短期利用を可能にすることで、研究室や実験段階にとどまっていたロボットを、生活や産業の現場により近づけることを目的としています。併設される「ロボット部品スーパー」では主要部品がそろえられ、故障時の即時修理や部品交換にも対応し、ユーザーの利便性と稼働率を高める仕組みが整っています。
オープニングイベントでは、ロボット産業を牽引する大手企業を含む26社が合同で調印式を行い、技術開発や市場拡大、産業標準化の推進に向けて協力することを確認しました。会場には人型ロボットやサービスロボット、ロボット犬などが展示され、来場者は関節の柔軟性や生活支援機能を体験しながら、実際に触れて動作を確認できるよう演出されました。従来、オンライン販売に依存していたロボット市場に対し、展示と販売を一体化することで、利用者がロボットの性能を直感的に理解できる新しいモデルを提示した形です。
同国では今後、6S店を拠点として産業チェーン全体の連携を強化し、研究成果を効率的に社会実装する動きが加速するとみられます。深圳市人工知能(ロボット)署は、この店舗をロボット商業化のショールームとして育成し、消費者向けロボット時代の本格的な幕開けを後押しする方針を示しました。これにより、ロボットが実験室や研究機関にとどまらず、一般家庭や産業現場へ普及していく可能性が一層高まっています。
参照中国深圳に世界初「ロボット6S店」誕生 体験・販売・修理を一体化|36Kr Japan